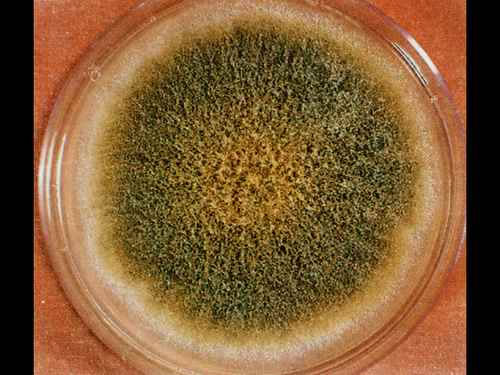

黃曲霉毒素的毒性非常高,是目前已發現霉菌毒素中毒性最大的一種。
黃曲霉毒素(Aflatoxins,簡寫AF)主要為黃曲霉和寄生曲霉的次生代謝產物。在溫暖與潮濕的氣候地區,凡是被黃曲霉和寄生曲霉污染過的糧食和飼料都可能存在黃曲霉毒素。最易受黃曲霉毒素污染的有花生、玉米、棉籽、禽蛋、肉、奶及奶制品等產品,其次是小麥、高粱和甘薯,而大豆豆粕污染黃曲霉毒素的程度略輕。在我國,糧食和飼料被黃曲毒素污染的概率很高,給飼料企業以及養殖業主帶來了很大的損失,而人們食用含有黃曲霉毒素的食物還會危害到身體健康。
黃曲霉毒素的理化特性
目前已經確定黃曲霉毒素的結構有AFB1、AFB2、AFM1等18種,它們的基本結構中都含有二呋喃環和氧雜萘鄰酮(又名香豆素)。黃曲霉毒素很難溶解于水、己烷、乙醚和石油醚,易溶于甲醇、乙醇、氯仿以及二甲基甲酰胺(DMF)等有機溶劑。黃曲霉的分子量為312~346,熔點為200~300℃,該毒素耐高溫,通常的加熱處理方式對其破壞性很小,只有在熔點的溫度下才會發生分解。黃曲霉毒素在遇堿情況下能迅速分解,但此反應可以實現逆還原,即在酸性的條件下又會復原。一般來說,溫度30℃、相對濕度80%、谷物水份在14%以上(花生的水份在9%以上)的條件最適合黃曲霉繁殖和生長。在24~34℃之間,黃曲霉菌產毒量最高。幾乎所有谷物、飼草和各種食品(包括畜產品)都可作為黃曲霉基質。
黃曲霉毒素對動物的危害
黃曲霉毒素的毒性非常高,是目前已發現霉菌中毒性最大的一種。目前發現的18種黃曲霉菌毒素家族中,AFB1的毒性最為強烈,AFM1、AFG1次之,AFB2、AFG2、AFM2毒性較弱。AFB1的毒性是砒霜的68倍,誘發肝癌的能力甚至比二甲基亞硝胺還要大75倍。其毒性大小因動物的種類、年齡、性別、體況及營養狀況的不同而有所差異,其中,年幼動物、雄性動物對其反應較敏感。
黃曲霉毒素具有很強的誘導突變、抑制免疫以及強致癌的作用。黃曲霉毒素起作用的靶器官主要是肝臟,動物的中毒癥狀以全身性出血、消化機能發生障礙及神經系統的紊亂為特征。急性中毒癥狀主要表現為食欲廢絕、運動失調、排泄停止、肝炎、黃疸,還包括肝臟充血、出血、腫大、變性和壞死,并且伴有比較嚴重的血管和中樞神經損傷,動物中毒后幾小時至幾天內死亡。動物慢性中毒的早期癥狀表現為食欲不佳,體重減輕,生產性能降低,后期出現黃疸、脂肪肝、肝損傷等現象,嚴重時會出現免疫機能喪失和患癌等病癥。
黃曲霉毒素對人類健康的危害
黃曲霉毒素被公認為強致肝癌的物質,其中黃曲霉毒素B1(AFB1)的致癌性最強。長期食用含有低水平黃曲霉毒素食物的人肝臟將受到較大損害。
有些第三世界的國家報道了許多會由黃曲霉毒素引起急性中毒的新證據,其綜合病癥的顯著特征為嘔吐、腹痛、肺水腫、驚厥、痙攣、昏迷,并且由大腦水腫引起死亡和肝臟、腎形礦脈和心臟的脂肪過多。1988年國際癌癥研究中心(IARC)將黃曲霉毒素B1列為人類的強烈致癌物之一,而許多亞洲和非洲的流行病研究者也證實了日糧黃曲霉毒素和肝細胞癌(LCC)有正效應。另外,人類因為黃曲霉毒素而致癌的幾率可能與年齡、性別、營養狀況以及肝或者寄生蟲感染有關。
冠宇儀器研制出真菌毒素檢測系統應用競爭抑制免疫層析的原理,通過檢測線熒光定量卡中的熒光強弱程度,定量分析待檢樣品中真菌毒素殘留含量。能夠快速定量檢測糧食、飼料、谷物、食用油、調味品等食品中黃曲霉毒素(T2毒素、嘔吐毒素、赭曲霉毒素、伏馬毒素、玉米赤霉烯酮,)含量。儀器不僅制作精良,而且操作簡單、采用熒光讀數,結果精準準確。采用熒光量子點技術,結合了膠體金快速、酶聯免疫定量以及色譜法準確的技術特點,可在8min內快速準確定量的測定出對應的項目。操作簡便,只需一步加樣,無需標準品,無需做標準曲線,結果準確可靠且可現場打印,準確性高度符合HPLC法的檢測結果,為霉菌毒素的快速現場檢測提供了一種全新的技術手段,適用于各類原料收儲、飼料加工企業、養殖企業及政府相關監管部門。
http://m.sh-xunning.cn/products-zh-2496.html





 微信掃一掃
微信掃一掃